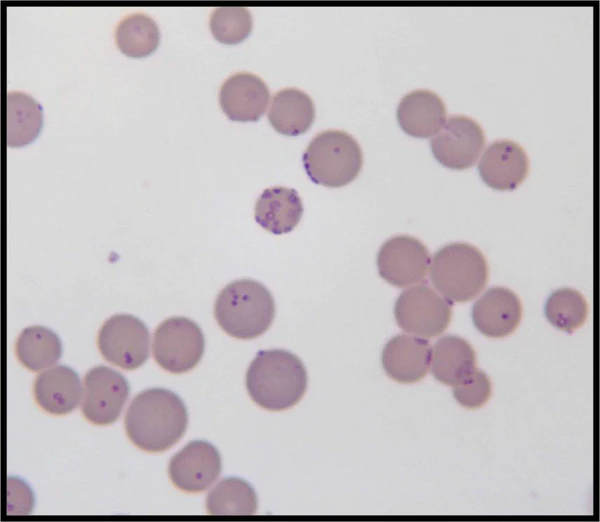

Микоплазмоз
Микоплазмо́з — группа инфекционных заболеваний человека, вызываемых бактериями рода Mycoplasma. Микоплазмы представляют собой класс бактерий, не имеющих клеточной стенки, колонизирующих слизистые оболочки дыхательных путей, глаз, желудочно-кишечного тракта, мочеполовой системы. Вне слизистых оболочек микоплазмы малоустойчивы к воздействию химических и физических факторов.
Что важно знать
| Микоплазма | |
|---|---|
| Научная классификация | |
| Международное научное название | |
| Mollicutes Edward and Freundt 1967 |
Этиология
Установлено, что на слизистых оболочках в организме человека могут обитать не менее 15 видов микоплазм[1]. Большинство микоплазм относят к условно-патогенным микроорганизмам, они могут присутствовать в организме здоровых людей, не вызывая развитие заболеваний[1].
Существует несколько разновидностей микоплазм, вызывающих у человека инфекции различной локализации. Mycoplasma pneumoniae является возбудителем респираторной инфекции или респираторного микоплазмоза, ряд других видов (Mycoplasma hominis, Mycoplasma genitalium и др.) являются возбудителями урогенитальных микоплазмозов[1].
По отношению к «типичным» возбудителям инфекций дыхательных путей (S. pneumoniae, H. influenzae, M. catarrhalis) M. pneumoniae относят к «атипичным» возбудителям[1].
Роль микоплазм и уреаплазм в развитии инфекций мочеполовой системы изучена недостаточно. Проведённые исследования показали, что различные виды микоплазм и уреаплазм могут быть причиной урогенитальных инфекций, преждевременных родов, случаев невынашивания беременности и других нарушений со стороны репродуктивной системы, также возможно внутриутробное инфицирование плода[2].
Mycoplasma genitalium может вызывать уретрит у мужчин и женщин, а также цервицит и воспалительные заболевания органов малого таза у женщин. Роль M. genitalium в развитии эпидидимита и простатита дискутабельна, убедительных доказательств нет[3].
Эпидемиология
Респираторный микоплазмоз чаще встречается в странах с умеренным климатом, эпидемические подъёмы заболеваемости отмечают каждые 4-8 лет. Инфекции, вызванные M. pneumoniae, могут возникать в любом возрасте, чаще всего среди детей в возрасте 5—17 лет и молодых людей[4].
В связи со сложностями диагностики, а также дифференциации между колонизацией и инфекцией, показатели заболеваемости и распространённости микоплазмоза весьма неопределённы и официальные статистические данные отсутствуют.
Отечественные исследователи полагают, что в структуре острых респираторных заболеваний доля инфекций, вызванных M. pneumoniae, составляет около 10—16 %, а во время эпидемических вспышек может достигать 30—40 %[4]. По данным популяционных исследований зарубежных стран (Германии, Дании, Финляндии, Японии, стран Африки) доля инфекций, вызванных M. pneumoniae, колеблется в диапазоне 4,9—67 %[5].
M. pneumoniae является достаточно распространённой причиной респираторных заболеваний, протекающих в лёгкой форме[6], и, по данным исследователей США, частой бактериальной причиной пневмонии у госпитализированных пациентов (наиболее распространённая причина пневмонии у детей и 2-я по распространённости причина у взрослых)[7].
При респираторном микоплазмозе заражение происходит воздушно-капельным путём (источник заражения — больные люди, роль здоровых бактерионосителей в качестве источника инфекции дискутабельна)[1][4]. Заболевание может возникать как спорадически, так и в виде эпидемических вспышек.
Заражение чаще происходит при тесном длительном контакте с больным человеком, что связано с нестойкостью возбудителя при его попадании в окружающую среду[4]. При кратковременном контакте инфицирование менее вероятно. Более склонны к инфицированию и развитию болезни люди с ослабленной иммунной системой, а также люди, выздоравливающие после других респираторных заболеваний[6].
Вспышки респираторного микоплазмоза обычно возникают в местах длительного пребывания большого количества людей и организованных коллективах (в школах, общежитиях, домах престарелых и др.). В условиях медицинских учреждений могут возникать госпитальные вспышки. Вспышки могут быть достаточно продолжительными из-за длительного инкубационного периода (1—4 недели), способности бактерий персистировать в дыхательных путях в течение нескольких месяцев и длительности симптомов (кашля).
Инкубационный период при респираторном микоплазмозе составляет от 3—7 дней до 4-х недель. Заразным периодом обычно считают 5—7 дней при инфекциях верхних дыхательных путей и до 2—3-х недель при микоплазменной пневмонии[4].
Урогенитальный микоплазмоз относят к инфекциям, передающимся преимущественно половым путём. Пути инфицирования M. genitalium: у взрослых людей — половой, у детей — интранатальный и половой. По данным разных исследователей, M. genitalium обнаруживают в 10—45 % случаев у людей с инфекционно-воспалительными процессами урогенитального тракта, в 7—10 % случаев — у женщин с инфекционно-воспалительными заболеваниями органов малого таза, в 11,5—41,7 % случаев при негонококковых уретритах и в 3—54,5 % случаев при негонококковых нехламидийных уретритах[3].
Патогенез
Патогенез инфекций, вызванных M. pneumoniae, включает прямое воздействие возбудителя на клетки и ткани организма, а также выработку ферментов, цитотоксические и аутоиммунные реакции[5]. M. pneumoniae обладает тропностью к эпителию слизистой оболочки дыхательных путей, с помощью адгезинов связывается с эпителиоцитами, повреждает их клеточную стенку и вызывает гибель клеток. Воспалительный процесс чаще развивается на уровне верхних дыхательных путей, реже распространяется на нижние дыхательные пути и ткань лёгких с развитием пневмонии. При микоплазменной пневмонии происходит дистрофия, деструкция и метаплазия альвеолярного эпителия, уплотнение межальвеолярных перегородок. В интерстициальной ткани лёгких возникают перибронхиальные и периваскулярные инфильтраты, в некоторых случаях в результате выраженного воспаления возможно развитие лёгочного фиброза[4]. Иммунитет после перенесённой респираторной микоплазменной инфекции непродолжительный, возможно повторное заражение.
M. genitalium обладает тропностью к цилиндрическому эпителию, может вызывать поражение слизистой оболочки уретры и цервикального канала[3].
Классификация
В зависимости от локализации патологического процесса выделяют:
- респираторный микоплазмоз,
- урогенитальный микоплазмоз,
- микоплазмоз других локализаций.
Клинические проявления
Респираторный микоплазмоз представляет собой группу инфекционно-воспалительных заболеваний органов дыхания, вызываемых M. pneumoniae. Микоплазменные респираторные инфекции, чаще всего, протекают в лёгкой форме, в виде инфекции верхних дыхательных путей (назофарингита, трахеита, бронхита), реже — в виде синусита, среднего отита, пневмонии.
Клинические проявления респираторного микоплазмоза неспецифичны и практически не отличаются от аналогичных инфекций другой этиологии[4][8].
Симптомы респираторного микоплазмоза обычно появляются через 1—4 недели после инфицирования и сохраняются в течение нескольких недель. Наиболее распространённые симптомы включают чувство слабости/усталости, лихорадку, головную боль, боль в горле, кашель. У некоторых инфицированных людей симптомы могут отсутствовать[7].
У детей младше 5 лет часто встречаются такие симптомы, как заложенность и выделения из носа, боли в горле, слёзотечение, хрипящее дыхание, диарея, рвота.
Начало заболевания при микоплазменной пневмонии может протекать в виде поражения верхних дыхательных путей с высокой лихорадкой на фоне незначительных симптомов интоксикации, через несколько дней появляется сухой кашель (навязчивый или приступообразный), который может сохраняться до нескольких недель.
При респираторном микоплазмозе осложнения встречаются редко, среди них — менингит, энцефалит, симптомы или приступы брохиальной астмы, гемолитическая анемия, нарушение функции почек, синдром Стивенса — Джонсона, индуцированные микоплазмой кожная сыпь и мукозит, а также нарушения со стороны пищеварительной системы.
Для урогенитального микоплазмоза характерно латентное и хроническое течение, широко распространено бессимптомное носительство микоплазм[5][2].
Среди клинических форм урогенитальных инфекций, вызванных M. genitalium, выделяют неосложнённые (уретрит, цервицит) и осложнённые (сальпингоофорит, эндометрит) формы. Клинические проявления урогенитального микоплазмоза неспецифичны, наиболее частые симптомы включают слизисто-гнойные выделения из уретры и/или наружных половых путей, зуд, жжение, болезненные мочеиспускания, боли в промежности и нижней половине живота, болезненность во время половых контактов. У более половины инфицированных женщин встречается бессимптомное течение урогенитального микоплазмоза[3].
Среди других клинических форм микоплазменной инфекции описаны поражение почек (гломерулонефрит), сердца (миокардит), суставов (артрит), нервной системы (менингит, менингоэнцефалит, полирадикулонейропатия), системы крови (гемолитическая анемия). Поражение центральной нервной системы при микоплазмозе, в основном, обусловлено M. pneumoniae и чаще развивается как осложнение респираторной инфекции[5].
Диагностика
В диагностике микоплазмоза используют микробиологические, иммунологические и молекулярно-биологические методы.
Материалом для исследования при респираторном микоплазмозе является мазок из носоглотки, мокрота и кровь. В отличие от некоторых других респираторных инфекций, методы экспресс-диагностики респираторного микоплазмоза не разработаны. В большинстве случаев респираторных инфекций (особенно при лёгком течении инфекций, а также в амбулаторных условиях) специфическую диагностику на наличие инфекции, вызванной M. pneumoniae, не проводят.
Микробиологические (культуральные) методы с целью диагностики применяют редко в связи с их высокой стоимостью, низкой чувствительностью и длительностью культивирования (от 1 до 6 недель).
Среди иммунологических методов чаще всего используют иммуноферментный анализ (определение уровня антител — иммуноглобулинов M и G к микоплазмам), реже реакцию агрегатгемагглютинации, материалом для исследования является сыворотка крови. Для оценки изменения (нарастания) титра антител иммунологические исследования проводят в динамике с интервалом в 10-14 дней. Недостатками этого метода является высокая частота ложно-положительных и ложно-отрицательных результатов.
Молекулярно-биологические методы позволяют обнаружить в исследуемом материале антиген возбудителя (с помощью иммунофлюоресценции) и его геном (с помощью полимеразной цепной реакции)[5][4].
Дифференциальную диагностику респираторного микоплазмоза проводят с другими инфекциями респираторного тракта (вызванными типичными возбудителями, хламидиями, легионеллами, пневмоцистами и др.).
При урогенитальном микоплазмозе преимущественно используют метод ПЦР, направленный на обнаружение специфических фрагментов ДНК и/или РНК, в качестве материала для исследования используют мазок из уретры и цервикального канала.
Лечение и профилактика
Большинство людей с лёгкой формой инфекции, вызванной M. pneumoniae, выздоравливают самостоятельно, без применения лекарств. Для облегчения состояния могут быть использованы безрецептурные симптоматические средства[6].
Для лечения микоплазменной инфекции используют антибактериальные средства, активные в отношении микоплазм (макролиды, фторхинолоны, тетрациклины)[6].
Препаратами выбора при терапии респираторного микоплазмоза являются макролиды (азитромицин, кларитромицин, джозамицин и др.)[6].
Мытьё рук, прикрывание рта при кашле и чихании, а также использование индивидуальных средств защиты могут помочь предотвратить распространение респираторных микоплазм.
Профилактика урогенитального микоплазмоза направлена на исключение случайных половых контактов, использование средств барьерной контрацепции, обследование и лечение половых партнёров.
Примечания
Литература
- Шаравий А. О., Смирнова С. В., Поликарпов Л. С., Игнатова И. А. Респираторный микоплазмоз // Дальневосточный медицинский журнал. — 2005. — № 4.
- Савенкова М. С., Савенков М. П. Респираторный микоплазмоз у детей // Лечебное дело. — 2008. — № 1.
- Батурин В. А., Щетинин Е. В. Диагностика и лечение респираторного микоплазмоза // Медицинский вестник Северного Кавказа. — 2007. — № 1.
- Заплатников А. Л., Майкова И. Д., Леписева И. В. Респираторный микоплазмоз в практике врача-педиатра // Медицинский совет. — 2016. — № 1.